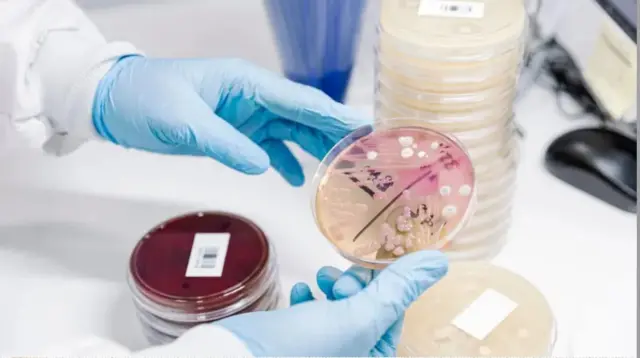
آگر

فینی انجلینا ہیس: وہ خاتون جنھوں نے باورچی خانے کے ایک جزو سے مائیکرو بایولوجی کی دنیا میں انقلاب برپا کیا

ایگر (جسے کبھی کبھی آگر بھی کہا جاتا ہے) ایشیائی کھانے میں ایک عام جزو ہے۔
ایگر کو گرم پانی میں گھول کر سوپ یا یخنی کے جیسے گرم محلول کو گاڑھا کرنے کے لیے استعمال کیا جاتا ہے۔ اس کی ایک اور خاصیت یہ بھی ہے کہ یہ میٹھے کو بھی نہ صرف گاڑھا کر کے اُسے ایک خاص شکل میں رہنے میں مدد کرتا ہے بلکہ اسے ایک مرتبہ جم جانے کے بعد دوبارہ پگھلنے سے بھی روکتا ہے۔
امریکی طبی تحقیق کے ادارے نیشنل انسٹیٹیوٹ آف ہیلتھ (این آئی ایچ) کے مطابق ایگر ایگر جیلی کی طرح کا وہ مادہ ہوتا ہے کہ جسے سرخی مائل ایک خاص سمندری گھاس سے حاصل کیا جاتا ہے۔ ادارے کے مطابق اسے نہ صرف کھانے بلکہ کاسمیٹک، دوا سازی، بایومیڈیکل اور بایو ٹیکنالوجی کی صنعتوں میں بھی استعمال کیا جاتا ہے۔
دوا سازی میں ’ایگر‘ کے استعمال کے بارے میں اگر سادہ الفاظ میں بات کی جائے تو ایگر کا استعمال زخم یا جلد پر لگائی جانے والی مرہم میں کیا جاتا ہے جس میں چکنائی موجود ہوتی ہے۔ مرہم میں موجود اس چکنائی یا جیل میں دوا کو شامل کیا جاتا ہے جو آہستگی کے ساتھ زخم کو بھرنے میں مدد کرتی ہے۔

،تصویر کا ذریعہGetty Images
تاہم باورچی خانے کی دنیا سے بہت دور سمندری گھاس سے حاصل کیا جانے والا یہ مادہ سائنس کی دُنیا میں ایک اہم مقام رکھتا ہے۔ یہ وہ معیاری ذریعہ ہے جس کی مدد سے فنگس اور بیکٹیریا کی لیبارٹری میں نشو نما کی جاتی ہے۔
چونکہ یہ پاؤڈر کے ساتھ ساتھ نیم ٹھوس حالت میں بھی پایا جاتا ہے اس لیے بیکٹیریا اس پر نہایت مؤثر انداز میں بڑھتا ہے۔
اس طرح آیگر کے ساتھ لیباٹری کی ایک پیٹری ڈش یعنی لیباٹری میں موجود چھوٹی شیشے کی پلیٹوں میں بیکٹیریا کی مختلف کالونیاں تیار ہو سکتی ہیں یعنی بیکٹیریا کے چھوٹے انفرادی گروہ ایک ہی جگہ پر موجود ہیں۔
پہلی نظر میں یہ ایک تکنیکی بات لگ سکتی ہے لیکن جیسا کہ سوئس فیڈرل لیبارٹریز فار میٹریلز سائنس اینڈ ٹیکنالوجی (ایمپا) کی ایک محقق ڈاکٹر وینیسا آیالانونیز بی بی سی منڈو کو بتاتی ہیں کہ ’یہ حیرت کی بات ہے کیونکہ اس کی نمو کو کنٹرول کرتے ہوئے آپ انھیں الگ تھلگ کر سکتے ہیں۔‘
End of سب سے زیادہ پڑھی جانے والی
اور یہ مطالعہ کرنے اور سمجھنے کے لیے ایک اہم قدم ہے کہ انفیکشن کیسے کام کرتا ہے، نیز تشخیص تک پہنچنے کے لیے یہ شناخت کرنا کہ کون سے بیکٹیریا بیماری کا سبب بن رہے ہیں علاج تلاش کرنے کا پہلا قدم ہے۔
ایشیائی کھانوں کا یہ بنیادی جزو تقریباً 140 سال پہلے لیبارٹریوں میں کیسے پہنچا؟
یہ فینی انجلینا ہیس کی بدولت تھا ایک ایسی خاتون جن کے بارے میں بہت کم لوگوں نے سنا ہے۔ جن میں بہت سے مائیکرو بایولوجسٹ بھی شامل ہیں۔

،تصویر کا ذریعہGetty Images
ٹیم ورک
سنہ 1850 میں نیویارک میں تارکین وطن جوڑے کے ہاں پیدا ہونے والی لینا، جیسا کہ ان کا خاندان انھیں پکارتا تھا ’انھوں نے ایک جرمن ڈاکٹر والتھر ہیس سے شادی کی جن سے ان کی نیویارک میں ملاقات ہوئی، جو پھیپھڑوں کی ایک نامعلوم بیماری پر تحقیق کر رہے تھے جس نے یورینیم کی کان کے کارکنوں کو متاثر کیا تھا اور جو بعد میں کینسر کے نام سے درافت ہوئی۔
یہ جوڑا آخر کار برلن چلا گیا، جہاں ہیس نے رابرٹ کوچ کی لیبارٹری میں کام کرنا شروع کیا (بعد میں مائیکروبایولوجی کی دُنیا میں ایک بڑے نام کے طور پر جانے جانے لگے اور تپ دق کی وجہ بننے والے بیسیلس کی نشاندہی کرنے پر 1905 میں فزیالوجی یا میڈیسن میں نوبل انعام کے فاتح ہیں)۔
اگرچہ والتھر خاندان میں ’آفیشل سائنسدان‘ تھے تاہم لینا اور اپنے شوہر کے ساتھ لیبارٹری میں شانہ بشانہ کام کرتے تھے۔
،تصویر کا ذریعہGetty Images
بی بی سی اردو کی خبروں اور فیچرز کو اپنے فون پر حاصل کریں اور سب سے پہلے جانیں پاکستان اور دنیا بھر سے ان کہانیوں کے بارے میں جو آپ کے لیے معنی رکھتی ہیں
سبسکرائب کرنے کے لیے کلک کریں
مواد پر جائیں
سنہ 1992 میں لینا اور ڈاکٹر والتھر ہیس کے پوتے وولف گینگ ہیس نے ایک مختصر سوانح عمری میں لکھا کہ ’گھر میں اپنے فرائض اور اپنے تین بچوں کی تعلیم کے علاوہ وہ والتھر کے سائنسی کام سے بہت حد تک واقف تھیں اور ان کی اس طرح مدد کرتی تھیں جیسے وہ ایک حقیقی تکنیکی معاون ہوں۔‘
کوراڈو نائی جو مائیکرو بایولوجی کے ڈاکٹر ہیں اور ایگر کے استعمال میں برسوں کا تجربہ رکھتے ہیں، انھوں نے بی بی سی منڈو کو بتایا کہ ’تکنیکی اعتبار سے لینا سائنسدان نہیں تھیں، لیکن اُن کا دماغ ایک سائنسدان کی طرح سوچتا تھا۔‘
’وہ ایک جرمن گھریلو خاتون تھیں لیکن جب کام اور تحقیق کی بات آتی تو وہ مل کر کام کرنے میں ماہر تھیں۔‘
"یہ وقت کی وجہ سے اور اس کے کردار کی وجہ سے نہیں ہو سکتا تھا (وہ ایک جرمن گھریلو خاتون تھی)، لیکن وہ ایک کام کرنے والی ٹیم تھے۔
نائی جو فی الوقت لینا ہیس کی زندگی کے بارے میں ایک گرافک ناول کی تیاری پر کام کر رہے ہیں اُن کے بارے میں کہتے ہیں کہ ’وہ اور اُن کے شوہر ایک ساتھ کام کرتے تھے مگر روایات کی وجہ سے اُن کے شوہر تحقیقی کام کو صرف اپنے ہی نام سے شائع کرتے تھے۔ لینا نے اپنے شوہر کی کامیابی میں اہم کردار ادا کیا۔ لیکن اس سب کے باوجود لینا نے اپنے کام کے شواہد جمع کیے اور اور سائنسی مثالیں ترتیب دیں۔‘
محقق ڈاکٹر وینیسا آیالانونیز کا کہنا ہے کہ ’یہ مثالیں ظاہر کرتی ہیں کہ ایک جاندار کیسے بڑھتا ہے، یہ کیسا لگتا ہے، اس کی شکل کیا ہے اور یہ ایک مائیکروجنزم کی شناخت کے عمل کا حصہ ہے۔‘
اور یہ کوچ کی لیبارٹری میں ایک ساتھ کام کر رہی تھیں۔ سنہ 1881 میں گرمیوں کے ایک دن بہت سے ناکام تجربات کے بعد جب انھیں آگر کو کلچر میڈیم کے طور پر جانچنے کا خیال آیا۔

،تصویر کا ذریعہESTATE OF DR. WOLFGANG HESSE, FAMILY PROPERTY
کچن سے لیبارٹری تک
ہوا میں مائیکروبیل آلودگی کی تحقیقات کرنے کے لیے والتھر نے انڈے کی سفیدی، چھینے (دودھ سے الگ ہونے والا پانی)، گوشت، آلو کے ٹکڑوں اور دیگر کھانوں کے علاوہ جیلیٹن کا استعمال کیا۔
لیکن بار بار بیکٹیریا نے جیلیٹن کو توڑ دیا اور گرمی نے ان کے تجربات کو پگھلا دیا۔
انھیں ٹھنڈا رکھنا کوئی حل نہیں تھا چونکہ اس کا مقصد ان بیکٹیریا کا مطالعہ کرنا تھا جو جسم میں بیماری کا سبب بن سکتے ہیں، اس لیے انسانی جسم کے درجہ حرارت کو لیبارٹری میں دوبارہ پیدا کرنا ضروری تھا۔
اور پھر لینا کو جاوا (سابق ڈچ کالونی، موجودہ انڈونیشیا) کے روایتی کھانوں میں استعمال ہونے والے ایک عام جزو آگر کو آزمانے کا خیال آیا جسے وہ سبزیوں کے ساتھ میٹھے اور دیگر پکوانوں کی تیاری میں برسوں سے استعمال کرتی رہی تھیں۔
وہ آگر اور انڈونیشیا کے کھانوں کے راز جانتی تھیں کیونکہ وہ آدھی ڈچ تھیں۔ وہ جانتی تھیں کہ آگر کی بدولت، میٹھے اپنی ساخت کو برقرار رکھتے ہیں چاہے وہ کتنا ہی گرم کیوں نہ ہو۔
یہ قطعی طور پر معلوم نہیں ہے کہ آیا یہ والتھر ہی تھے جنھوں نے لینا سے پوچھا کہ انھوں نے اپنے میٹھوں کو زیادہ درجہِ حرارت پر کیسے مضبوط بنایا یا یہ لینا ہی تھیں جنھوں نے جلیٹن کو آگر سے بدلنے کا مشورہ دیا۔
نائی کہتے ہیں ’لیکن، یقینی طور پر، ’وہ وہی تھیں جو آگر کے بارے میں جانتی تھی، وہ اس خیال کی ذمہ دار تھیں‘۔

،تصویر کا ذریعہESTATE OF DR. WOLFGANG HESSE, FAMILY PROPERTY
کوچ کو خط
جوڑے نے ایگر کا تجربہ کیا، اس کے فوائد دریافت کیے، اور فوری طور پر کوچ کو خبر دی، جو اس وقت 19 ویں اور 20 ویں صدی کے اوائل میں صنعتی ممالک میں موت کی سب سے بڑی وجہ تپ دق کے بارے میں اپنی تحقیق پر مرکوز کیے ہوئے تھے۔
کوچ نے 1882 میں بتایا کہ تپ دق ایک بیکٹیریا کی وجہ سے ہے جس نے اس کی تشخیص اور علاج کی راہ ہموار کی۔
اور اگرچہ اسی سال اس نے ایک کانفرنس میں مائیکروبیکٹیریم تپ دق کی دریافت میں آگر کے کردار کا ذکر کیا تھا لیکن اس میں نہ تو لینا کا نام تھا اور نہ ہی والتھر ہیس کا۔
نائی کہتے ہیں کہ ’یہ پہلا موقع تھا جب آیگر آیگر سائنسی ادب میں نمودار ہوا۔‘
لیکن مائیکرو بایولوجسٹ نہیں سمجھتے کہ ہیس کو نظر انداز کرنا ایک قسم کا ’خراب سائنسی رویہ‘ تھا، بلکہ یہ جزوی طور پر اس لیے تھا کہ کوچ نے ابھی تک یہ تسلیم نہیں کیا تھا کہ یہ ثقافتی ذریعہ یعنی آیگر کتنا اہم ہے۔
نائی کہتے ہیں’اسی متن میں وہ کہتے ہیں کہ، ان کی رائے میں، آیگر خون کے سیرم کے ساتھ کام نہیں کرتا۔‘
یہ ایک بتدریج عمل تھا جب تک کہ لیبارٹری میں ایگر کی قدر کو تسلیم نہیں کیا جاتا۔
مزید یہ کہ والتھر نے آیگر پر کوئی مطالعہ شائع نہیں کیا اور نہ ہی انھوں نے اور نہ ہی لینا نے اپنی دریافت کو پیٹنٹ کرنے کی کوشش کی۔
وولف گینگ اپنے دادا دادی کی سوانح عمری میں لکھتے ہیں ’ہیسس کو اپنی ’ایجاد‘ کے لیے کبھی کوئی مالی انعام نہیں ملا اور نہ ہی انھوں نے اس معاملے کو تجارتی طور پر استعمال کرنے پر غور کیا۔ یہ مناسب نہیں تھا۔‘
آیالانونیز کہتی ہیں کہ ’انھوں نے شناخت کی تلاش نہیں کی۔ انھوں نے اسے صرف ایک تکنیکی صورت حال کو حل کرنے کے طریقے کے طور پر لیا جو کہ بہت اہم تھی۔‘
’اور بعض اوقات، لیبارٹری میں، جب کوئی چیز تکنیکی ہوتی ہے تو اسے بہت کم کر دیا جاتا ہے لیکن سچ یہ ہے کہ اس حصے کے بغیر سائنس کا وجود ہی نہیں ہے۔‘
آج آیگر ایک ایسی پروڈکٹ جو سستی بھی ہے اور تیار کرنے میں بھی آسان ہے تمام مائیکروبایولوجی لیبارٹریوں میں استعمال ہونے والا ایک بنیادی عنصر ہے۔












